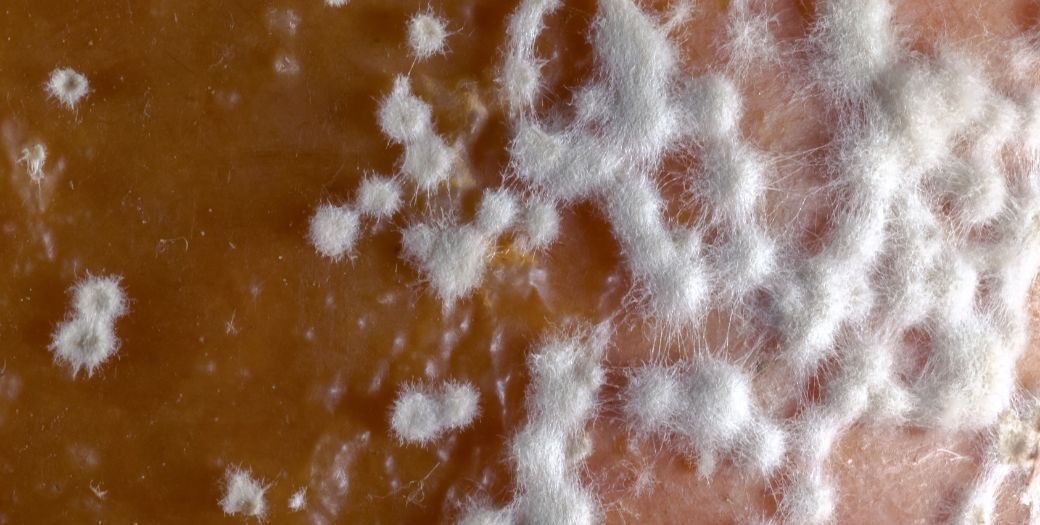

High humidity not only makes floors sticky and unpleasant but also easily creates musty odors, affecting the health of your family. If your home doesn't have a dehumidifier, don't worry, try these extremely simple methods below!
How can I reduce the humidity in my room during the summer?
The answer lies in your daily habits and the items you already have at home. To keep your house dry and airy, you need to combine good air circulation with the use of natural dehumidifying methods.
1. Always keep your house well-ventilated
The easiest way is to open the windows to let natural breezes in, pushing the moisture out. Areas like bathrooms and kitchens need to have doors open or fans running for longer periods to prevent lingering odors.
2. Use electric fans correctly
Turning on a fan not only cools the room but also helps circulate the air, promoting faster evaporation of moisture. This is a very effective and inexpensive way to reduce room humidity.
3. Utilize natural moisture-absorbing materials
Charcoal, baking soda, or dried coffee grounds are indispensable. Simply put them in a cloth bag and hang it in a corner of the room; they will automatically absorb moisture and eliminate odors very effectively

Reduce humidity in air-conditioned rooms
Many people wonder if using an air conditioner helps dry out their house. In fact, it reduces humidity in the room extremely quickly. When the Dry mode (water droplet icon) is activated, the air conditioner will remove moisture from the air, instantly creating a dry space without needing to buy a separate dehumidifier.
How to reduce humidity in a baby's bedroom
For rooms with young children, pay special attention to humidity to avoid respiratory illnesses.
Limit drying clothes indoors; absolutely do not hang wet clothes in your child's bedroom.
Cleaning carpets is essential, as carpets accumulate moisture and mold. Vacuum regularly and keep them dry. Finally, use cold water when bathing your child; this will remove a lot of steam from the hot water. After bathing, open the windows to help the room dry quickly.
Additionally, you can read more about the ideal humidity level for a newborn's room in the article "What is the right humidity level for a newborn's room?" for more details on humidity for your baby's room.
So, what are the ideal temperature and humidity levels for a room?
According to research, the ideal room temperature and humidity are around 25-28 degrees Celsius with humidity between 40% and 60%. Is a humidity level of 80% considered high or low? This is a very high level, easily leading to mold and bacterial growth. You should immediately apply the tips above to bring the humidity back to a safe level.
To know exactly when to take measures to combat humidity, investing in a small hygrometer or other specialized indoor humidity measuring devices is also a good idea. If you see a reading exceeding 70%, open windows for ventilation or turn on the air conditioner immediately to protect your family's health.





